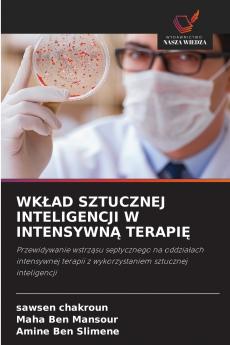
WKŁAD SZTUCZNEJ INTELIGENCJI W INTENSYWNĄ TERAPIĘ

Polish
Paperback
₹5170
(All inclusive*)
Delivery Options
Please enter pincode to check delivery time.
*COD & Shipping Charges may apply on certain items.
Review final details at checkout.
Looking to place a bulk order? SUBMIT DETAILS
About The Book
Description
Author(s)
Wczesne wykrycie wstrząsu septycznego ma kluczowe znaczenie dla poprawy wyników leczenia pacjentów. Niniejsze badanie ma na celu opracowanie modelu uczenia maszynowego wykorzystującego XGBoost do przewidywania wstrząsu septycznego z sześciogodzinnym wyprzedzeniem. Model został wytrenowany na publicznym zbiorze danych obejmującym 40 336 pacjentów. Przetestowano go na części tego zestawu osiągając dokładność 097 i AUC 0874. Wykonano również prognozy na 8 10 i 12 godzin do przodu uzyskując dokładność 0899 0891 i 08954 oraz AUC odpowiednio 0867 08639 i 08530. Ponadto model został przetestowany na lokalnym zbiorze danych ze Szpitala Uniwersyteckiego Fattouma Bourguiba obejmującym 30 pacjentów. W przypadku 6-godzinnego przewidywania na lokalnym zbiorze danych model osiągnął dokładność 089 i AUC 074. Prognozy na 8 10 i 12 godzin do przodu wykazały dokładność 08861 08772 i 08718 oraz AUC odpowiednio 073 072 i 072. Model XGBoost wykazuje potencjał do wczesnego wykrywania wstrząsu septycznego ale wymaga dalszych testów i optymalizacji do zastosowań klinicznych.
Delivery Options
Please enter pincode to check delivery time.
*COD & Shipping Charges may apply on certain items.
Review final details at checkout.
Details
ISBN 13
9786208695583
Publication Date
-27-02-2025
Pages
-52
Weight
-85 grams
Dimensions
-152x229x3.16 mm